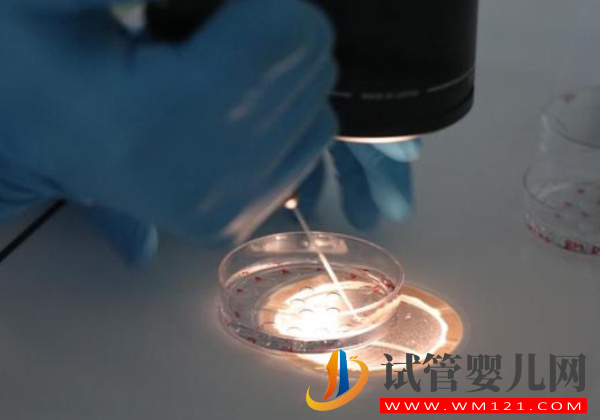
試管移植后熱水泡腳的3大好處匯總，水溫、時間把控好才有用(圖1)

?
黄色一级视频免费观看|
亚洲国产精品久久久久秋霞影院|
奇门遁甲1982国语版免费观看高清
|
糖心vlog精品一区二区|
久久女人天堂|
最新日韩av在线|
亚洲人成77777|
国产麻豆一区二区三区精品|
影音先锋日韩在线|
欧美高清视频一区二区|
日本三级网站在线观看|
欧美成人a交片免费看|
色狠狠av一区二区三区|
九九热精品在线播放|
最新精品视频在线|
久久久精品一品道一区|
亚洲美女视频网|
在线视频 日韩|
成年人视频在线看|
国产精品久久二区二区|
蜜臀av.com|
www.夜夜操.com|
狠狠色伊人亚洲综合成人|
成人亚洲综合色就1024|
一级特黄aaa|
亚洲高清极品|
国产一区二区精品丝袜|
91插插插插插插|
欧美日韩尤物久久|
欧美成人vr18sexvr|
国产熟妇搡bbbb搡bbbb|
国产美女高潮在线|
91精品婷婷国产综合久久竹菊|
中文字幕在线观看免费高清|
国产一区二区三区免费观看在线
|
日韩激情一区二区|
爱情岛论坛亚洲入口|
免费a级毛片永久免费|
国产精品扒开腿做爽爽爽软件|
亚洲free嫩bbb|
亚洲人的天堂男人爽爽爽|
亚洲天堂激情|
国产精品免费在线播放|
亚洲精品影视在线|
久久综合五月|
国产91社区|
free欧美性|
国产在线一区二区综合免费视频|
椎名由奈jux491在线播放|
天天草天天操|
国产亚洲精品福利|
91精品国产91久久久久麻豆 主演|
韩国福利在线|
亚洲高清视频的网址|
成人在线电影网站|
精品捆绑调教一区二区三区|
久久精品国产一区二区三区
|
91免费精品国偷自产在线在线|
韩日精品中文字幕|
www.久久视频|
日韩av密桃|
国产91成人video|
一级黄色短视频|
一二三区不卡|
狠狠色综合欧美激情|
美女喷水网站|
久久一二三国产|
草草久久久无码国产专区|
国产一二在线观看|
777xxx欧美|
日本一级淫片免费放|
亚洲乱码免费伦视频|
国产精品偷伦视频免费观看国产|
国产亚洲精品拍拍拍拍拍|
久久网站热最新地址|
日韩在线不卡一区|
污网站在线免费看|
日韩免费一区二区三区在线播放|
自拍偷拍欧美亚洲|
水蜜桃精品av一区二区|
成人黄色片在线|
九九热视频在线|
亚洲精品国产一区二区精华液
|
免费黄色网页在线观看|
欧美精品在欧美一区二区少妇|
久久免费公开视频|
日韩精品水蜜桃|
国产久一道中文一区|
97碰碰碰免费公开在线视频|
精品久久久久久久久久|
国产中年熟女高潮大集合|
国产精品亚洲欧美日韩一区在线
|
日本激情一区|
成人h视频在线|
jizzjizzwww|
亚洲成人动漫一区|
天天摸日日摸狠狠添|
日韩大陆av|
欧美成人午夜剧场免费观看|
久久全国免费久久青青小草|
国产精品网曝门|
亚洲av无码久久精品色欲|
不卡专区在线|
欧美成人激情视频免费观看|
全免费a级毛片|
国产精品免费免费|
在线观看欧美一区二区|
日韩精品一区二区三区中文字幕|
国产精品日韩精品|
大肉大捧一进一出好爽|
超级白嫩亚洲国产第一|
亚洲欧洲在线免费|
中文字幕av网站|
国内一区二区三区|
欧美日韩成人在线视频|
成人久久久精品国产乱码一区二区
|
中文字幕在线免费不卡|
国产免费一区二区三区网站免费|
国产成人精品一区二区免费看京
|
亚洲欧洲国产综合|
国产精品一区二区在线观看不卡|
一区二区三区网址|
日韩中文影院|
欧美日本高清一区|
999人在线精品播放视频|
一区二区三区四区高清精品免费观看|
欧美成人精品欧美一级乱黄|
国产成人aaa|
超碰在线97免费|
日韩电影大全网站|
日本国产高清不卡|
加勒比一区二区三区|
欧美日韩国产综合视频在线观看
|
口述被爽到呻吟高潮自述|
精品久久久精品|
黄色大片网站在线观看|
亚洲国产高清一区|
欧美国产二区|
免费人成黄页在线观看忧物|
国产午夜精品全部视频播放|
人人草人人干|
欧美影院一区二区|
日本韩国欧美中文字幕|
欧美亚韩一区|
亚洲欧美精品|
波多野结衣乳巨码无在线观看|
91国语精品自产拍在线观看性色
|
国产综合图区|
激情av一区二区|
一级黄色大片视频|
亚洲激情社区|
av在线免费观看国产|
成人性生交大片免费看网站|
国产精品免费一区|
四虎国产精品永远|
亚洲第一区中文字幕|
精品欧美在线观看|
成人avav影音|
国内精品视频在线播放|
中文字幕在线资源
|
瑟瑟视频在线|
国产一区二区日韩|
国产黄色免费|
亚洲国产va精品久久久不卡综合|
国产精品怡红院|
成人18精品视频|
90岁老太婆乱淫|
日韩一区二区在线免费|
国产精品视频网站在线观看|
成人直播在线观看|
国产一区精品在线|
1stkiss在线漫画|
色小说视频一区|
高潮一区二区三区乱码|
中文字幕在线观看不卡|
日本少妇性生活|
国产成人a级片|
亚洲一区二区自偷自拍|
国产日韩亚洲|
国产在线观看欧美|
精品国产丝袜高跟鞋|
久久精品91久久香蕉加勒比|
国产视频青青|
欧美草草影院在线视频|
777片理伦片在线观看|
第一福利永久视频精品|
午夜精品免费观看|
国产精品1区二区.|
丝袜熟女一区二区三区|
欧美三区视频|
日韩不卡一二三|
日韩欧美精品一区|
无罩大乳的熟妇正在播放|
中文字幕一区二区三区中文字幕
|
精品无码m3u8在线观看|
国产精品77777|
www.涩涩爱|
国产日韩一区二区三区在线|
中文人妻一区二区三区|
伊人成人在线|
91丝袜超薄交口足|
日韩电影在线视频|
丰满人妻中伦妇伦精品app
|
免费成人深夜蜜桃视频|
亚洲美女色禁图|
中文字幕视频三区|
国产欧美一区二区三区精品观看|
蜜臀视频一区二区三区|
日韩欧美美女在线观看|
手机在线观看国产精品|
av岛国在线|
国产精品91在线观看|
中文字幕网在线|
久久久精品国产|
992tv在线观看免费进|
亚洲欧洲在线视频|
av网站免费看|
亚洲精品电影网在线观看|
亚洲日韩色图|
欧美精品在线一区二区|
欧美人与z0zoxxxx特|
欧美在线色视频|
手机在线观看免费av|
国产精品美女一区二区在线观看|
国产精品一级黄片|
欧美午夜在线|
激情av中文字幕|
国产精品99一区二区|
日本特黄在线观看|
欧美成人69av|
超碰在线97免费|
欧美精品网站|
69xxx免费视频|
日韩精品久久久久久|
黄色aaa视频|
国产激情视频一区二区三区欧美|
五月天婷婷导航|
国产精品久久久久久久午夜片|
91中文字幕在线播放|
精品国产福利在线|
久久婷婷综合中文字幕|
日韩视频在线永久播放|
国内精品免费视频精选在线观看
|
波多野结衣在线观看|
久久亚洲一区二区|
午夜羞羞小视频在线观看|
亚洲最大成人网色|
色尼玛亚洲综合影院|
一区二区三区欧美成人|
白嫩亚洲一区二区三区|
亚洲国产精品一区在线观看不卡|
国产精品一区二区三区av麻|
国产精品一区二区人妻喷水|
99久久综合色|
国产一级特黄aaa大片|
国产精品黄色在线观看|
91在线精品入口|
色综合久久久久久久|
可以免费观看的毛片|
欧美日韩午夜影院|
亚洲线精品久久一区二区三区|
精品亚洲一区二区|
美女桃色网站|
久久精品国产一区|
在线免费观看黄色网址|
国产精品视频免费观看www|
欧美freesex黑人又粗又大|
国产精品国产三级国产专区53|
99久久人爽人人添人人澡|
欧美日韩在线免费播放|
国产精品毛片|
杨钰莹一级淫片aaaaaa播放|
亚洲综合免费观看高清在线观看|
免费久久网站|
亚洲人成电影网站色…|
伊人国产在线看一|
欧美丰满片xxx777|
成人午夜在线影视|
不卡一卡2卡3卡4卡精品在|
中文字幕日韩亚洲|
免费毛片小视频|
亚洲在线久久|
偷拍夫妻性生活|
久久久久99精品一区|
亚洲国产www|
欧美日韩久久一区二区|
狠狠插狠狠操|
性视频1819p久久|
99热99re6国产在线播放|
亚洲欧美国产一区二区|
日韩国产一区二区三区|
少妇户外露出[11p]|
91免费看片在线观看|
91黑人精品一区二区三区|
欧美日韩精品国产|
你懂的在线观看视频|
久久久久五月天|
成人在线网址|
日本高清一区|
欧美男人操女人视频|
欧美黄色一级片视频|
国产精品a级|
欧美性猛交xxxx乱大交少妇|
亚洲精品高清视频在线观看|
俺去啦最新官网|
日本免费一区二区三区视频观看|
亚洲电影有码|
av黄色在线网站|
亚洲国产日本|
国产乡下妇女做爰视频|
亚洲精品国产视频|
国产精品伦一区二区三区级视频频
|
美腿丝袜亚洲一区|
久久久久无码精品国产|
性欧美疯狂xxxxbbbb|
国产日韩网站|
欧美激情日韩图片|
亚洲一区资源|
欧美黑人在线观看|
国产精品亚洲欧美|
在线能看的av|
欧美日韩三级视频|
中文字幕123|
都市激情久久久久久久久久久|
97精品国产一区二区三区|
精品一区二区在线观看视频|
色综合av在线|
视频免费在线看|
国产欧美一区二区|
伊人久久综合网另类网站|
天天干天天av|
99精品久久只有精品|
午夜精品久久久久久久第一页按摩|
中文字幕日韩av综合精品|
欧美成年黄网站色视频|
一本久久a久久精品vr综合
|
亚洲第一色视频|
国产亚洲精品一区二区|
天堂8中文在线|
国产免费黄色小视频|
日韩视频中文|
免费在线观看黄色小视频|
91麻豆国产香蕉久久精品|
国产欧美日韩综合精品一区二区三区|
日韩精品在线私人|
av免费在线观|
亚洲熟妇无码一区二区三区|
99久久国产综合精品麻豆|
黄网站在线观看永久免费|
欧美激情二区三区|
福利一区二区免费视频|
欧美在线观看视频网站|
成人综合婷婷国产精品久久|
永久免费黄色软件|
性欧美办公室18xxxxhd|
国产一区二区三区精品在线观看|
久久中文字幕精品|
欧美日韩一区二区免费视频|
国产日韩精品在线看|
日本在线观看一区二区三区|
一区二区日韩免费看|
最新黄色网址在线观看|
日韩精品免费看|
99re在线视频|
精品人妻人人做人人爽|
极品少妇一区二区|
亚洲色图 校园春色|
国模私拍视频一区|
香蕉成人影院|
欧美久久久久久久久久久|
最新日韩av在线|
aaaaa毛片|
超碰在线观看97|
综合视频在线|
亚洲男人天堂网址|
国产午夜精品免费一区二区三区|
超碰国产精品一区二页|
日本黄色片在线播放|
亚洲桃色在线一区|
黄色网址免费|
97国产超碰|
国产精品免费大片|
久久伊人成人网|
精品日韩一区二区三区免费视频|
惠美惠精品网|
免费在线观看的毛片|
91浏览器在线视频|
日本羞羞视频|
av观看久久|
国模大胆一区二区三区|
97精品人妻一区二区三区香蕉|
国内久久久精品|
亚洲男人都懂第一日本|
久久精品国产av一区二区三区|
国产亚洲精品91在线|
成人午夜在线|
国产小视频自拍|
欧美日韩精品三区|
国产视频中文字幕在线观看|
一区二区三区四区影院|